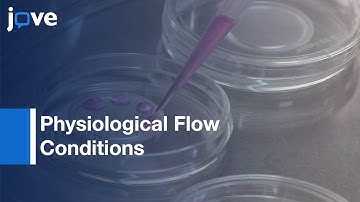
Novel 3D Flow Chamber Device: Chemokine-Directed Extravasation-Cells Circulating l Protocol Preview

⬇ DOWNLOAD NOW
Kalau muncul iklan pop-up, tutup lalu klik tombol kembali
Download lagu How to Create a Custom Template with the CM30 Incubation Monitoring System secara gratis hanya untuk keperluan promosi. Dukung artis favorit kamu dengan membeli musik original di iTunes atau platform resmi lainnya.
 How to Set Up a New Project with the CM30 Incubation Monitoring System
How to Set Up a New Project with the CM30 Incubation Monitoring System
 Take Your Research 3D in 3 Easy Steps
Take Your Research 3D in 3 Easy Steps
 Harvest Organoids from ECM - Quick, efficient 10 min protocol. High recovery of intact organoids.
Harvest Organoids from ECM - Quick, efficient 10 min protocol. High recovery of intact organoids.
 BT37 Mark II - For consistent humidified culturing
BT37 Mark II - For consistent humidified culturing
 InoMATRIX protocols - Cell seeding
InoMATRIX protocols - Cell seeding
 Meet the Modular Incubator Chamber (MIC-101)
Meet the Modular Incubator Chamber (MIC-101)
 MSU Cell Biology (BIO320) - Cell Culture Tips for Trypsin Incubation (Video 4)
MSU Cell Biology (BIO320) - Cell Culture Tips for Trypsin Incubation (Video 4)
Novel 3D Flow Chamber Device: Chemokine-Directed Extravasation-Cells Circulating l Protocol Preview
Novel 3D Flow Chamber Device: Chemokine-Directed Extravasation-Cells Circulating l Protocol Preview